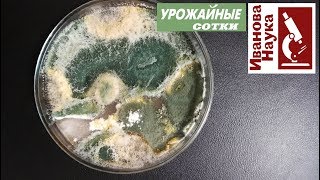

КАК САЖАТЬ ЧЕСНОК ПОД ЗИМУ И ЧТОБЫ БЫЛ КРУПНЫЙ ПРАВИЛЬНО
Чтобы правильно сажать чеснок под зиму и получить крупные головки, следуйте следующим рекомендациям:
1. Выберите подходящую для чеснока почву. Она должна быть рыхлой, плодородной и хорошо дренированной.
2. Планируйте посадку на конец осени, когда почва остынет, но время от посадки до наступления морозов будет достаточным.
3. Подготовьте грядку, удалите сорняки и перекопайте почву, добавив компост или перегной для улучшения её питательных свойств.
4. Разделите чеснок на отдельные зубки перед посадкой. Выбирайте крупные и здоровые зубки для получения крупных головок.
5. Расстояние между рядами должно быть около 30 см, а между сами зубками – 10-15 см в ряду.
6. Посадите зубки вертикально с острым концом вниз на глубину около 3-5 см.
7. Накройте грядку мульчей, чтобы защитить посадки от заморозков и сохранить влагу в почве.
8. После посадки обеспечьте регулярный полив, особенно в период отсутствия осадков.
9. Весной, когда почва прогреется и начнется активный рост чеснока, удобряйте его органическими удобрениями.
10. Собирайте чеснок после того, как его зеленые стрелки начнут желтеть и сохнуть. Вынимайте его из почвы осторожно, чтобы не повредить головки.
Следуя этим советам, вы сможете успешно посадить чеснок под зиму и получить крупные и вкусные головки.
НОВЫЙ СПОСОБ!ПОСАДКА ЧЕСНОКА ЦЕЛЫМИ ГОЛОВКАМИ!Я В ВОСТОРГЕ ОТ РЕЗУЛЬТАТА!
Чеснок, посаженый ЭТИМ способом, ОЧЕНЬ удивит вас урожаем!
Чтобы вырастить крупный чеснок, когда сажать? Как выбрать чеснок на посадку? Хранение чеснока зимой
Когда и как сажать чеснок под зиму
Осенняя посадка чеснока от \
Как вырастить чеснок. Всё просто - дерзайте! Крупный чеснок без проблем!
ОЧЕНЬ КРУПНЫЙ ЧЕСНОК, МУЛЬЧИРОВАНИЕ ЧЕСНОКА ОСЕНЬЮ